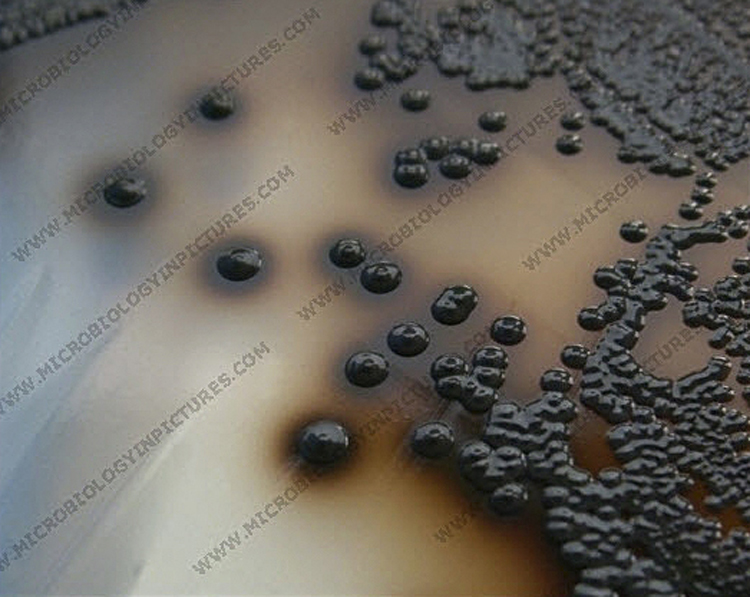

Francisco de Goya Y Lucientes
March 30, 1746, Fuendetodos (Zaragoza), Spain – April 16, 1828, Bordeaux, France
Goya is one of the most characteristic Spanish artists of all time and also one of the best European painters and engravers of the 19th century. His enormous and highly varied output of paintings, drawings, and engravings, depicting many aspects of everyday life, provide a good insight into a period of political and social unrest in Europe during the Napoleonic years. He was a genius and a revolutionary artist who influenced the artistic movements from Romanticism and Realism to Impressionism. ♦ Croup (El garotillo) ♦
A doctor examines a sore throat and feels the inflamed area with his fingers.
♦ Diagnosis
Main symptoms: Sore throat, rough barking cough
Secundary symptoms: Boy, breading difficulties
Clinical diagnosis: laryngeal diphtheria, croup
♦ Definition: diphtheria
An infectious disease caused by Corynebacterium diphtheriae, which forms a characteristic false membrane on the mucous membranes of the throat, larynx, and trachea and, in rare cases, also on the conjunctiva or vagina.
The disease causes local pain, swelling, and discomfort.
The toxin causes fever, exhaustion, heart damage, and sometimes paralysis or death.
♦ Definition
Diphtheria used to be a common and deadly disease, but widespread preventive vaccination has made it so rare that many doctors have never encountered it.
However, diphtheria is still a major cause of illness in large parts of Asia and Africa.actor.
Immediate treatment of the disease is so important for the patient that a doctor should always consider the possibility of diphtheria when examining a patient complaining of a sore throat. Sudden heart failure, caused by the myocardial toxicity of diphtheria toxin, is responsible for most deaths.
Another interesting and more plausible explanation for this work was suggested in 1997 by L.F. Grymer and W. Pirzing.
When compiling the inventory of Goya's work in 1812, it was reported that painting no. 25, entitled “El Lazarillo de Thormes,” was given to his son.
Lazarillo is a young boy who guides a blind man. Thormes is a city in Castillo, Spain. For this reason, it is more likely that this painting should be interpreted as follows.
Ël Lazarillo de Thormes is an anonymous Spanish novella from the 16th century. It tells the story of Lazarillo's daily life. Goya's painting refers to a chapter in this novella. The blind man gives the young boy a sausage to roast. The hungry rascal could not resist his hunger and gobbled up the sausage. Instead of the sausage, he put a turnip on the fire. When the blind man discovered the deception and the boy denied the deceitful switch, he stuck two fingers in the boy's mouth to smell the aroma of the swollen sausage with his long nose. The man's stranglehold caused the pain grimace visible in the boy's averting eyes.
Source: Jan Dequeker
Diphtheria
formerly known as croup, is a contagious, serious infectious disease caused by a bacterium (Corynebacterium diphtheriae), which is transmitted from person to person through coughing. Before vaccination became commonplace, diphtheria was one of the most common causes of death in children.
The bacteria produce a poisonous substance, also known as a toxin, which damages tissues such as the skin or lungs. The location of the infection determines which symptoms the patient will experience. The time between infection and the first symptoms appearing is usually 2-5 days, never longer than 7 days.
What does Corynebacterium diphtheriae look like under a microscope and on a blood agar plate and a Tinsdale agar plate?
♦♦♦ Corynebacterium diphteriae
Microscopic examination:
Are gram-positive rods, arranged in a palisade or Chinese character or V-shape.
Bacterial culture:
Bloodagar:
The bacteria grows with white colonies.
Tinsdale agar: (selective agar)
The bacteria grows with black colonies
Medische Microbiology & Infectious Diseases (MMIZ)
Loes van Damme
ErasmusMC hospital
Rotterdam